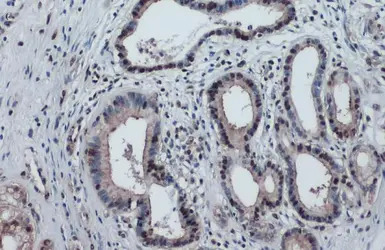
产品细节图片3
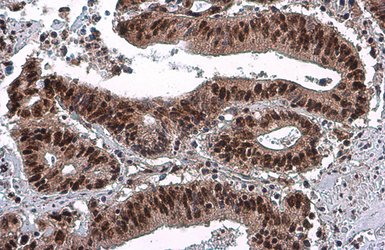
产品细节图片5

相关产品推荐更多 >
万千商家帮你免费找货
0 人在求购买到急需产品
- 详细信息
- 文献和实验
- 技术资料
- 免疫原:
Carrier-protein conjugated synthetic peptide surrounding phospho Ser46 of human p53. The exact sequence is proprietary.
- 亚型:
IgG2a
- 形态:
Liquid
- 保存条件:
Store as concentrated solution. Centrifuge briefly prior to opening vial. For short-term storage (1-2 weeks), store at 4ºC. For long-term storage, aliquot and store at -20ºC or below. Avoid multiple freeze-thaw cycles.
- 克隆性:
Monoclonal
- 标记物:
Unconjugated
- 适应物种:
Human
- 保质期:
12 months from the shipping date of the product.
- 抗原来源:
Human
- 目录编号:
GTX634168
- 级别:
Primary Antibodies
- 库存:
Available
- 供应商:
GeneTex
- 宿主:
Mouse
- 应用范围:
WB, ICC/IF, IHC-P
- 浓度:
1 mg/ml (Please refer to the vial label for the specific concentration.)
- 靶点:
p53 (phospho Ser46)
- 抗体英文名:
p53 (phospho Ser46) antibody [GT1018]
- 抗体名:
p53 (phospho Ser46) 抗体 [GT1018]
- 规格:
100 μl/25 μl
| 规格: | 100 μl | 产品价格: | ¥4000.0 |
|---|---|---|---|
| 规格: | 25 μl | 产品价格: | ¥1700.0 |

p53 (phospho Ser46) antibody [GT1018] detects p53 (phospho Ser46) protein at cytoplasm and nucleus by immunohistochemical analysis.
Sample: Paraffin-embedded human pancreatic cancer.
p53 (phospho Ser46) stained by p53 (phospho Ser46) antibody [GT1018] (GTX634168) diluted at 1:200.
Antigen Retrieval: Citrate buffer, pH 6.0, 15 min

p53 (phospho Ser46) antibody [GT1018] detects p53 (phospho Ser46) protein at nucleus by immunofluorescent analysis.
Sample: 293T cells were fixed in 4% PFA at RT for 15 min.
Green: p53 (phospho Ser46) protein stained by p53 (phospho Ser46) antibody [GT1018] (GTX634168) diluted at 1:200.
Blue: Hoechst 33342 staining.
Scale bar = 10 μm.
p53 (phospho Ser46) antibody [GT1018] detects p53 (phospho Ser46) protein at cytoplasm and nucleus by immunohistochemical analysis.
Sample: Paraffin-embedded human pancreatic cancer.
p53 (phospho Ser46) stained by p53 (phospho Ser46) antibody [GT1018] (GTX634168) diluted at 1:200.
Antigen Retrieval: Citrate buffer, pH 6.0, 15 min

Untreated (–) and treated (+) 293T whole cell extracts (30 μg) were separated by 10% SDS-PAGE, and the membrane was blotted with p53 (phospho Ser46) antibody [GT1018] (GTX634168) diluted at 1:1000. The HRP-conjugated anti-mouse IgG antibody (GTX213111-01) was used to detect the primary antibody.
p53 (phospho Ser46) antibody [GT1018] detects p53 (phospho Ser46) protein at cytoplasm and nucleus by immunohistochemical analysis.
Sample: Paraffin-embedded human colon cancer.
p53 (phospho Ser46) stained by p53 (phospho Ser46) antibody [GT1018] (GTX634168) diluted at 1:200.
Antigen Retrieval: Citrate buffer, pH 6.0, 15 min

p53 (phospho Ser46) antibody [GT1018] detects p53 (phospho Ser46) protein at cytoplasm and nucleus by immunohistochemical analysis.
Sample: Paraffin-embedded human ovarian cancer.
p53 (phospho Ser46) stained by p53 (phospho Ser46) antibody [GT1018] (GTX634168) diluted at 1:200.
Antigen Retrieval: Citrate buffer, pH 6.0, 15 min
风险提示:丁香通仅作为第三方平台,为商家信息发布提供平台空间。用户咨询产品时请注意保护个人信息及财产安全,合理判断,谨慎选购商品,商家和用户对交易行为负责。对于医疗器械类产品,请先查证核实企业经营资质和医疗器械产品注册证情况。
 文献和实验
文献和实验Xu P et al., Cell Prolif 2023 (PMID:36480593)
Using Phospho‐Motif Antibodies to Determine Kinase Substrates
comprising both the phosphorylated residue and the surrounding residues that determine kinase specificity, with degenerate residues taking up the remaining positions. Currently, several categories of phospho?motif antibody are commercially available
kinase is KIR 3.1 and have developed a phospho-selective antibody against the Y12 motif of this channel. Much like KOR and p38 MAP kinase, phosphorylation of this potassium channel increases following repeated stress. The following chapter discusses
secondary antibody review -- data from 99 publications
cytometry used as a control to detect cell responses targeted antigen 7 Alexa Fluor 488 7 Cy3 8 goat IgG Alexa Fluor 488 1:2000 detect antibody binding in human embryonic kidney 293T cells Invitrogen 9 donkey
 技术资料
技术资料暂无技术资料 索取技术资料






![MITF antibody [C5]](https://img1.dxycdn.com/2022/0328/231/9725721427343300453-14.jpg!wh200)




